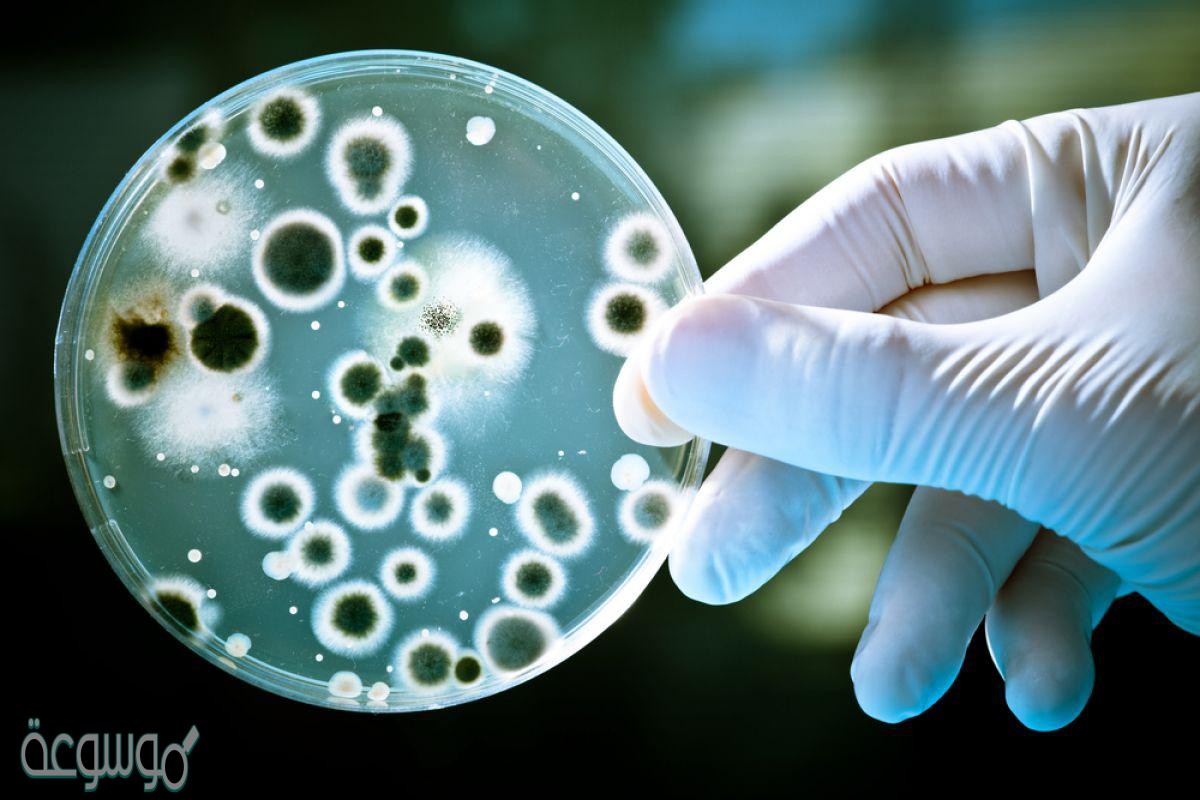

علم يهتم بدراسة المخلوقات الحية، يُعد هذه من العلوم المُهمة التي ساعدت في دراسة العديد من التفاصيل المُهمة والتي عبّرت عن الوظائف الهيكليّة للإنسان وساعدت هذه في تطور النمو والحفاظ على مجموعة من التصنيفات المُتنوعة التي ترتبط ما بين العديد من الفروع العامة فيها، كذلك تمكن هذه العلم من دراسة التفاصيل والبحوث العلميّة الدقيقة التي بينت سلسلة من التجارب العامة في حياة الإنسان، وساعد هذه العلم في تحديد التركيب الخلوي لجميع الاشكال في الحياة واهتم هذه العلم في دراسة تصنيفات الكائنات الحيّة وتطوير السلوك العلمي لها واضافة التنوع المعلوماتي الذي يستفيد منه الشخص بشكل عام، وسنقدم لكم ما هو الـ علم يهتم بدراسة المخلوقات الحية.
علم يهتم بدراسة المخلوقات الحية
تميز هذه العلم في مجموعة من الفروع المُتنوعة فيه التي ساهمت في استخدام مجموعة من الأساليب الجديدة في دراسة التفاصيل العامة التي أفاد بها هذه العلم، كذلك تميز هذه في بناء التجارب الجديد والتفاعلات المُعقدة في التي يُمكن أنّ تحصل في حياة الشخص، عمل هذه على تحديد بعض من الجزيئات البيولوجيّة والتي اختصت في علم النبات والدراسة المُختلفة فيها، ودّرس هذه العلم مجموعة من أجزاء الخليّة والوحدات البنائية لها وتوظيف العديد من الوظائف الفيزيائيّة والكيميائيّة والأنسجة التي يشملها الكائن الحي، يمكن القول أنّ علم الأحياء ساعدت على تحقيق التفاعل الكبير في بناء الأنظمة البيئيّة واحداث التفاعل ما بين الكائنات الحيّة والبيئيّة بشكل عام، وسنوضح لكم ما هو العلم الذي يهتم في دراسة المخلوقات والكائنات الحيّة.
ما هو العلم الذي يهتم بدارسة المخلوقات الحية
يُعتبر هذه من العلوم المُهمة والتي تميزت في دراسة الكائنات الحيّة بكافة أشكالها وفق عدّة من الخصائص العامة فيها والتي تقوم على مبدأ التنظيم والحاجة إلى الطاقة التي تساعد على ابراز النمو فيها والتكاثر في جميع انتاجات أفراد الخليّة الجديدة لها، كذلك استطاعت هذه في تمييز الكائنات الحيّة والقدرة على الاستجابة التي تحملها المؤثرات الخارجيّة على هذا العلم بشكل عام، ساعدت هذه على تحقيق التكيف العام وبناء عدّة من المُتطلبات البيئيّة التي يعيش فيها الإنسان بشكل عام، وأما بالنسبة لعلم يهتم في دراسة المخلوقات الحيّة.
- حلّ السؤال: علم الأحياء.
يُذكر أنّ علم الأحياء ينقسم إلى مجموعة من الأقسام والفروع المُتعددة والتي ساعدت على زيادة الإنتاجيّة لدى الكائنات الحيّة، ومن هذه العلوم علم النباتات وكذلك الأحياء والوراثة والبيولوجيا وعلم الحيوان والكائنات الحيّة، وقدمنا لكم علم يهتم بدراسة المخلوقات الحية.